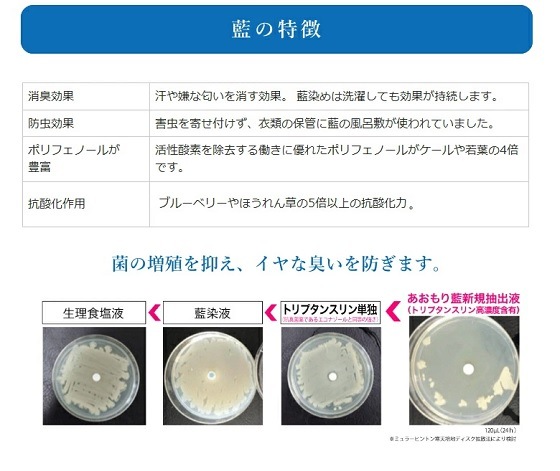
あおもり藍スプレー 80ml

あおもり藍スプレー 80ml
あおもり藍 消臭・抗菌スプレー 80ml
スペースシャトル搭載品実績を持つ服飾ブランド「あおもり藍」
その天然の抗菌性に着目し、農薬不使用のあおもり藍から抽出した天然成分により無臭除去に成功しました。
製造には全て食品グレードの天然由来成分100%でアルコールや界面活性剤を一切使用しておりません。
直接肌にかかっても心配ありませんので、赤ちゃんやペットのいるご家庭などでも安心安全にご使用いただけます。
■使用方法:お部屋・洗濯物(生乾き)・トイレ・台所・生ごみ・ブーツやシューズ、ベットや寝室・体臭・ミドル脂臭・加齢臭・足臭・車内・カーペット・カーテン・ソファ・帽子・バック・マフラー・手袋・ペット周り・水槽・切り花の長持ち・使用後のおむつ他、臭いが気になる部分へ軽く振ってから直接スプレーください。
■有効成分:あおもり藍抽出液(トリプタンスリン)
■ご注意点:人に直接スプレーする場合には、目に入らぬようご注意ください。万が一、目に入ってしまった場合は、水やお湯で洗って下さい。皮革類へもご使用いただけますが、何度もスプレーするとシミになる場合がございます。製造は全て食品グレードの原料を用いておりますが、飲料としての試験は行なっておりませんのでお飲みになれません。天然由来100%ですのでご購入後半年程度を目安に使いきりください。(成分に変わりはありませんが香りが薄くなります)
数量
¥1,265(税込)